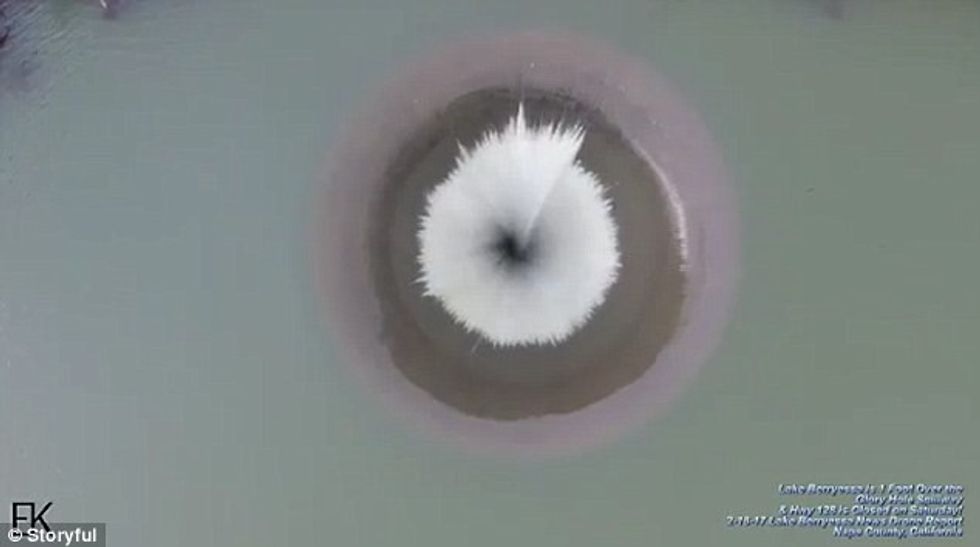
2 241

Spektakli i “Gropës së shenjtë” (Foto/Video)

Një fenomen i jashtëzakonshëm është shënuar në Kaliforni, teksa shirat e rrëmbyeshëm kanë shënuar rekordin e tyre në këtë zonë.
Niveli i liqenit u ngrit në maksimum ku dhe u shfaq dhe fenomeni i një grope të madhe që thith ujin.
Pamjet e filmuara me dron tregojnë liqenin Berryessa në kontenë Napa pas fundit të stuhisë. Në pamje duket uji që thithet nga gropa e madhe, ndërsa niveli kishte shkuar në 135 metra, rekordi i dytë i shënuar në historinë e tij.
Kjo lloj grope është krijuar për të ndaluar ujin të përmbytë tokat e Monticello Dam, duke e futur në kanalin kullues. Kjo gropë ka një diametër 23 metra dhe një thellësi 60 metra, kur niveli arrin mbi 135 metra, transmeton tch.
Hera e fundit që uji është futur në “gropë” ishte një dekadë më parë, në maj të 2006. Duke punuar me kapacitet të plotë kjo gropë mund të thithë 1370 litra ujë në sekondë. Ky rezervuar furnizon me ujë të pijshëm rajonin e North Bay në San Francisco.